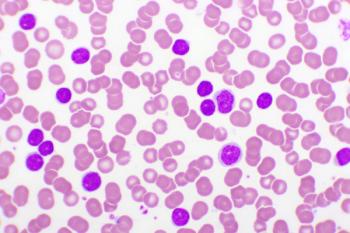

Researchers found that depression and anxiety may skew patient perceptions of participating in blood cancer clinical trials, thus contributing to low enrollment throughout the United States.

Researchers found that depression and anxiety may skew patient perceptions of participating in blood cancer clinical trials, thus contributing to low enrollment throughout the United States.

A phase 2 trial of aspacytarabine (BST-236) was initiated in patients with AML and MDS.

Study results showed that CPI-613 did not improve survival in patients with metastatic adenocarcinoma of the pancreas.

On this episode of the “Cancer Horizons” podcast, CURE® contributor Amanda Ferraro describes what it was like to receive a cancer diagnosis at 28 years old with a 3-year-old child and discusses the importance of mental health for cancer survivors.

An abundance of clinical trials is giving patients with acute myeloid leukemia (AML) hope for a better future.

Patients who are immunocompromised, such as patients with blood cancers, may get the boosted immunity needed to reduce their risk for contracting COVID-19 and hospitalization for compilations related to the virus.

“We are fortunate now to live in an era where we have nine new drugs approved (for AML) just in the last five years,” says an expert from The University of Texas MD Anderson Cancer Center.

“More and more (patients and physicians) need to work together in partnership throughout the cancer journey in order to optimize and make the journey the best possible that we can for every single patient,” says an expert from the Roswell Park Comprehensive Cancer Center.

A woman shares the story of her journey with multiple cancer types, including the same one that her mother died from.

Introducing integrated palliative care to patients with a certain type of leukemia was shown to facilitate active coping strategies, which could improve a patient’s quality of life.

Scientists have identified a potentially valuable genetic target in children with acute myeloid leukemia that could lead to further studies in immunotherapy drugs for the disease.

An analysis of more than 3.5 million children born between January 1996 and December 2016 demonstrated a stronger association between Down syndrome and acute myeloid leukemia risk than has been previously reported.

Treatment with a novel therapy as a single agent, or in combination with Venclexta, demonstrated a manageable safety profile and antileukemic effects in patients with relapsed/refractory acute myeloid leukemia. The study authors, however, note that more research is needed.

Compared to a hypomethylating agent alone, combining the agent with Venclexta improved complete remission rates in patients with blast-phase myeloproliferative neoplasm.

Patients with blood cancers are at a much higher risk of complications if they contract COVID-19, says an expert from the Leukemia & Lymphoma Society (LLS).

Patients with acute myeloid leukemia experience post-traumatic stress disorder symptoms including intrusion, avoidance and hypervigilance one month after diagnosis.

The agency granted approval to the revised label of Vyxeos to now include treatment for newly diagnosed therapy-related acute myeloid leukemia or disease with myelodysplasia-related changes in pediatric patients aged 1 and older.

This week on the “CURE Talks Cancer” podcast, we spoke with Nicole Schulz, who was diagnosed with acute myeloid leukemia at the age of 14, about how her life changed as a result of her treatment and why she now lives life to the fullest.
Onureg, an oral form of the chemotherapy azacitidine, in older patients with acute myeloid leukemia who were in remission after chemotherapy contributed to longer survival outcomes, compared to placebo.

The FDA has lifted a partial clinical hold on a phase 2 trial evaluating a novel therapy in patients with acute myeloid leukemia following an allogenic stem cell transplant.

Here is a list of some recent trials that launched within the cancer space in December.

Here are the top 10 FDA oncology drug approvals that you may have missed this year.

A roundup of some of the most read news and updates in acute myeloid leukemia in 2020 from CURE®.

In this episode of the “CURE Talks Cancer” podcast, Dr. Dan Pollyea discusses the basics of AML, as well as treatment options currently available for patients.

Watch our Acute Myeloid Leukemia Webinar where an expert panel discussed topics highly relevant to patients, caregivers and advocates right now.